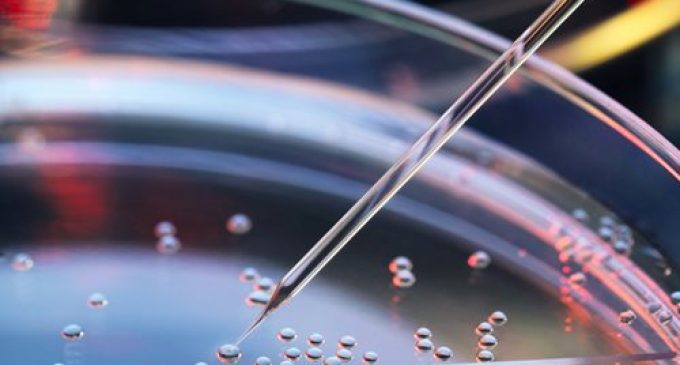

AstraZeneca to invest €65 million in biologic manufacturing, research and development in Ireland
Alexion, AstraZeneca’s Rare Disease group, has announced a €65 million investment in new and enhanced capabilities across its sites in College Park, Blanchardstown and Monksland Industrial Park, Athlone. The programme will centre on three investments: the installation of new drug substance production equipment and warehousing facilities to support ambient and cold storage at both sites in College Park and Athlone; and the construction of a Manufacturing Sciences & Technology Lab at College Park.
The equipment and warehouse facility in each site will expand Alexion’s drug substance production capabilities in Ireland. The Alexion Manufacturing Sciences & Technology Lab at College Park will facilitate scaling up of biologics drug substance manufacturing in Ireland. This development programme in Ireland follows last year’s announcement to build a next generation active pharmaceutical ingredient facility at AstraZeneca’s College Park campus.
Marc Dunoyer, Chief Executive Officer, Alexion, said: “We are delighted to be further investing in our facilities in Ireland, an increasingly critical global hub for AstraZeneca operations, to support the continued growth of Alexion’s portfolio of medicines and meet our needs for expansion. This investment will allow for new capabilities for AstraZeneca in Ireland and support our global ambition to accelerate the development and delivery of life-changing medicines for more people affected by rare diseases.”
Tánaiste and Minister for Enterprise, Trade and Employment Leo Varadkar TD said: “This is really fantastic news and a real boost to Ireland as a global hub for life sciences. This €65 million investment by Alexion, AstraZeneca’s Rare Diseases group, is a testament to the talent and skills we have in Blanchardstown and Athlone, and will significantly expand the company’s production capabilities here. It’s also great for our research bodies and will make a major contribution to the overall expertise we have based here. I wish the teams involved the very best of luck and thank both Alexion and AstraZeneca for their commitment to Ireland.”
Martin Shanahan, CEO IDA Ireland, said: “Ireland’s ambition is to be at the forefront of driving the future of biopharma. Today’s announcement to continue to increase Alexion capabilities in Ireland further demonstrates the company’s commitment to the rich life science ecosystem Ireland has to offer. The future of biopharmaceuticals lies in R&D and manufacturing opportunities, growth in advanced therapeutics, building employment opportunities in specialised roles and a commitment to a patient-centric, partnership approach.”




















